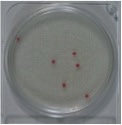

Mikrobiologiske vandanalyser som egenkontrol

Der er naturligvis nogle gode arbejdsregler man bør tage til sig, for at sikre sig at man får korrekte resultater.
Egenkontrol styrker det enkelte vandværk gennem at vandværket selv sætter fokus på steder, hvor ting kan gå galt. Selv med verdens bedste egenkontrol er der ingen garanti for, at det ikke går galt, men jo bedre en egenkontrol man har etableret, jo hurtigere opdager man fejlen og vil kunne iværksætte en korrigerende handling, således at forbrugeren udsættes for minimal risiko.
Mikrobiologiske vandanalyser er normalt noget, som overlades til akkrediterede laboratorier, og det skal man naturligvis forsætte med, idet loven kræver, at de obligatoriske prøver, typisk 1-2 om året, skal testes på et akkrediteret laboratorie. Der er dog intet i lovgivningen, der forbyder et vandværk i at tage flere prøver og sende til laboratoriet, eller at man etablerer et mini laboratorium, så man selv kan følge den mikrobiologiske status på vandværket.
Metoderne, der findes tilgængelige i dag, er tilsvarende dem som anvendes på akkrediterede laboratorier og kræver udelukkende, at man har et lille varmeskab.
• Sørg for at udtage din prøve korrekt, se hvordan den eksterne prøvetager fra et akkrediteret laboratorie udtager prøven.
• Hvis du ønsker at tage en prøve, sammen med den som går til et akkrediteret laboratorium, for at sammenligne resultater, bør du tage den umiddelbart efter deres prøve, undgå helst at vandet slukkes imellem.
• Før du åbner prøveflasken for at tilsætte pulveret, bør du desinficere dit arbejdsbord og vaske/desinficere dine hænder. Sørg for at få låget på hurtigt efter tilsætning af pulver og ryst forsigtigt, før du sætter prøven i varmeskabet.
• Tjek med jævne mellemrum, med et andet termometer, om dit varmeskab står på 37 grader.
• Aflæs dine 37 graders resultater (Coliforme, E. coli og Kim 37) efter 24 timer (evt. også efter 48 timer).
• Aflæs dine 22 graders resultater (Kim 22) efter 3 døgn
• Enhver blåfarvning af vandprøvekoppen betyder, at den er positiv for Coliforme, og hvis den fluorescerer under UV-lys, er den positiv for E. coli.
Som grundregel er der ingen grund til at UV belyse prøver, der ikke er blevet blå. E.coli er nemlig også en Coliform.
![]() |
![]() |
• Ved aflæsning af kim 37 og kim 22 tæller man kun røde kolonier efter 3 døgn.
Eksempel 1: 6 CFU/ml.

Eksempel 2: + 1000 CFU/ml.
Typiske grunde til at man vil få anderledes resultater end det akkrediterede laboratorie kan være:
• Prøveforskel
Man tester aldrig nøjagtig samme prøve, derfor kan/vil der være forskel; forestil dig en situation hvor der er én E. Coli tilstede pr. 1 liter vand. Når vi udtager 100 ml til prøve, vil vi i teorien kun finde den hver 10 gange. Det akkrediterede laboratorium kan være heldige at finde den, og du gør ikke eller omvendt du finder den, de gør ikke. I praksis er det ofte meget sporadiske forureninger vandværker oplever, specielt når problemet lige er indtruffet, er forureningen lav, og derfor kan resultater med fx kun 1. E.coli/100 ml, være svære at genfinde.
• Finder du en positiv prøve, bør du altid tage en ny prøve og være ekstra forsigtig omkring din håndtering af prøven, så du er sikker på, at du ikke selv har forurenet prøven. Brug en helt ny prøvekop der stadig er indpakket, vask/desinficer dine hænder inden du åbner posen og tag vandprøven uden at røre ved indersiden af kop eller låg. Sæt låget på så hurtigt du kan efter at du har fyldt vand op til stregen.

Ved spørgsmål kontakt DVN eller Food Diagnostics.

